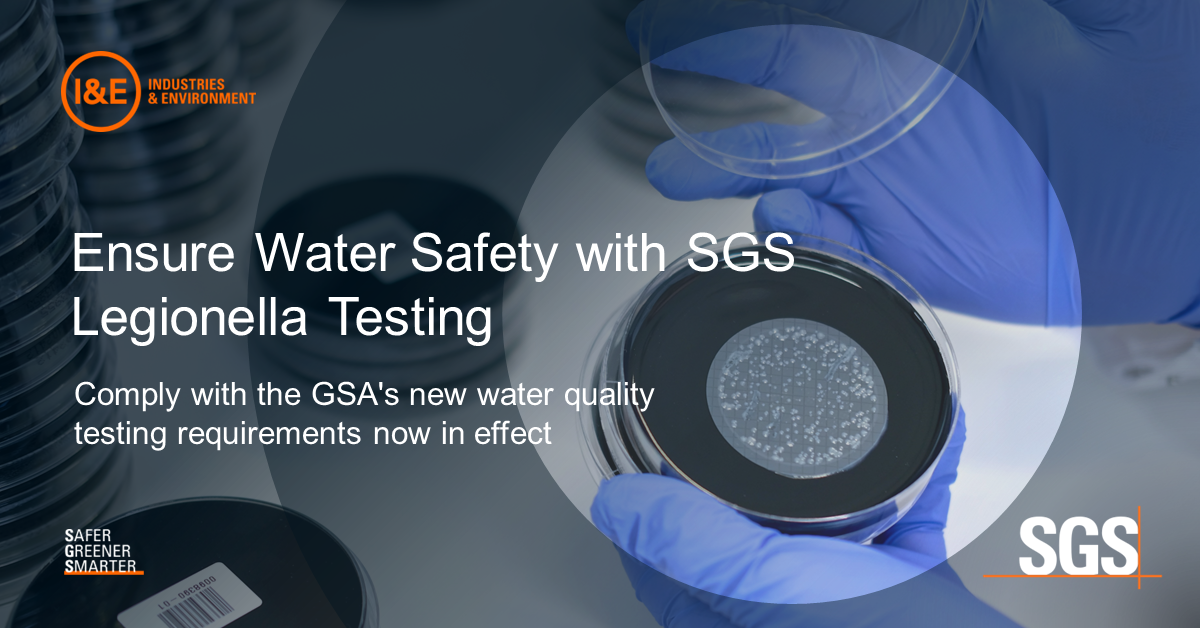

Important Update: Comply with New GSA Water Quality Testing Requirements
The U.S. General Services Administration (GSA) has enacted new requirements for baseline water quality testing in existing leases, addressing critical water stagnation concerns, including the risk of Legionella. As these regulations continue to roll out, it’s crucial to act quickly to ensure compliance and the safety of your facilities.
Why Choose SGS for Legionella Testing?
Comprehensive Analysis and Expertise: Our North American network of laboratories offers a wide range of Legionella testing services designed to meet both proactive and responsive needs. Our Hayward, CA and Las Vegas, NV laboratories are CDC ELITE-certified, committing to the highest standards of accuracy and reliability. With SGS you’ll find:
- Innovative Testing Methods: We utilize the latest PCR (Polymerase Chain Reaction) method for rapid response and initial screening. This advanced technique allows for the quick detection of Legionella, providing you with timely information to take necessary actions.
- Reliable Follow-Up: When a positive result is reported, we follow up with traditional culture-based analysis to confirm and quantify the presence of Legionella. This dual approach ensures thorough and accurate results.
- Experienced Laboratories: Our Hayward laboratory has been CDC ELITE certified since 2011, and our Las Vegas laboratory since 2015, showcasing years of proven excellence.
Understanding Legionella
Legionella is a bacterium naturally found in freshwater environments such as streams, lakes, and mud. However, it can also colonize human-made water systems like cooling towers, building water systems, evaporative condensers, and recreational structures such as jacuzzies and fountains. With the increased refinement of testing methods, incidences of Legionella contamination are being reported more frequently in these human-made environments.
Act Fast: Submit Your Samples Now
To comply with GSA regulations and ensure the safety of your water systems, we encourage you to submit your samples to our labs within 48 hours for the most accurate results.
- ISO 11731 Method Compliance: For samples from more remote areas, we can extend the holding time up to 5 days, provided they are kept under proper cooling conditions.
Choose a leader in Legionella testing with the capability to deliver rapid, reliable, and comprehensive results. Contact us today to schedule your water quality testing and ensure your facilities are safe and compliant.
Contact our Client Service Representatives in a number of different ways:
- Call toll-free +1 888 398 7002
- Email [email protected]
- Visit www.sgsgalson.com/legionella/